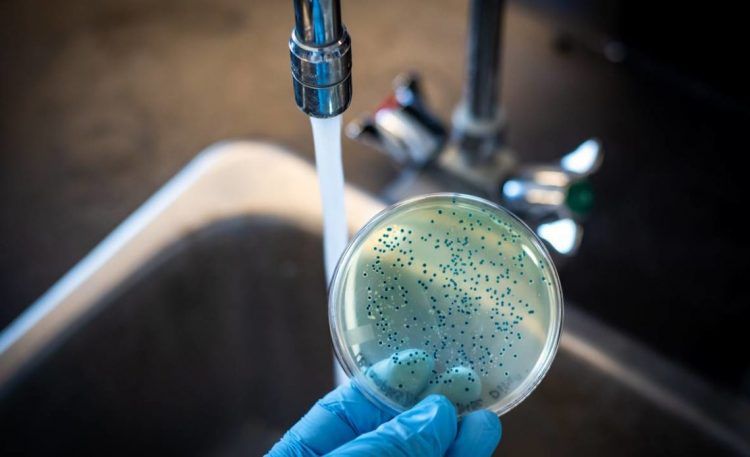
Salud Pública registra seis nuevos casos de cólera en el país

El Ministerio de Salud Pública notificó este miércoles seis nuevos casos de cólera, con lo que asciende a 71 el total de casos confirmados en el país.
Según explicó el doctor Eladio Pérez, viceministro de Salud Colectiva, los nuevos registros corresponden a cuatro masculinos entre 47, 45, 33 y 3 años de edad, así como dos femeninas, una de 69 y otra de 25 años.
Asimismo, indicó que estos casos fueron detectados en las Áreas IV y I de Salud, donde se presenta el foco de la enfermedad hasta el momento.
Manifestó que otros 40 casos sospechosos de cólera fueron descartados, los cuales de igual manera se sitúan en los sectores de Villa Liberación, El Almirante, Ensanche Luperón, y Villas Agrícolas.
Vacunación contra el cólera
La doctora Lucía Vargas, directora de Inmunoprevenibles por Vacunas, expresó que hasta la fecha se han vacunado a unas 21,087 personas.
De los cuales, se han vacunado 5,700 privados de libertad del centro carcelario La Victoria y 1,065 de Rafey.
El resto de esta inmunización se sigue aplicando al personal de salud, sectores priorizados por vulnerabilidad y en la frontera.
«Continuamos con las intervenciones oportunas y hasta el día de hoy no hemos encontrado casos diarreicos agudos ni con características de cólera en las visitas que hemos realizado, pero continuamos con la vacunación en las escuelas, vigilancia en los mercados ya que en algunos de ellos se han encontrado productos vencidos y en las zonas que no tenían agua se les ha suministrado», puntualizó Gina Estrella, directora de Atención de Riesgos y Desastres.

Tú que opina de este post